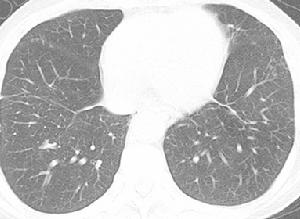

大連大學附屬中山醫院介入治療科主任
張躍偉,教授,主任醫師,碩士研究生導師,享受大連市政府特殊津貼。大連市醫學會放射介入專業委員會副主任委員,遼寧省細胞生物學學會常務理事、遼寧省細胞生物學學會腫瘤細胞生物學專業委員會副主任委員,大連市醫學會醫療事故技術鑑定專家庫成員。1993年和1996年分別畢業於哈爾濱醫科大學醫學影像學(本科)和介入神經外科(碩士)專業。曾獲“大連市青年職工創新創效能手”、“大連市第三屆青年科技獎” 、“全國衛生部青年崗位能手”等稱號,入選遼寧省百千萬人才“千層次”人才。獲得省部級科技進步二、三等獎各一項,大連市科技進步一、二等獎各1項。2008年在國內外率先套用國產明膠海綿微粒治療原發性肝癌和肝轉移癌的臨床和基礎研究,良好療效與歐美國家套用DC載藥微粒作為栓塞劑治療原發性肝癌相似。研究成果已在世界癌症大會(2011年)、第二屆亞太腫瘤介入大會暨第十二屆中國腫瘤介入大會(2011年)、第一屆、第二屆、第三屆中國腫瘤介入與微創治療大會(2010、2011及2012年)、第四屆全國介入醫學工程大會(2011年)等國內外學術大會上做主題講座。主持《血管內治療症狀性腦血管痙攣的臨床及臨床基礎研究》、《經局部腦動脈移植神經幹細胞治療缺血性腦損傷的實驗研究》、《聯合套用基因製劑-P53經區域動脈化療栓塞治療進展期胃癌的臨床研究》、《局部注射P53-基因製劑與血管內化療藥物灌注序貫治療胰腺癌的臨床研究》等省部及市局級科研課題5項。開展《B超引導下經皮經肝門靜脈穿刺序貫注射P53基因製劑和化療藥物治療原發性肝癌伴發門靜脈癌栓》等新技術6項。在《中華放射學雜誌》、《中華神經外科雜誌》等國家級刊物發表文章20餘篇。
科室治療特色:
大連大學附屬中山醫院介入治療科是以微粒栓塞腫瘤供血動脈治療各種實體良惡性腫瘤為核心技術,輔以細胞生物、基因、免疫、分子靶向、中藥等多種綜合治療手段,尤其提出並遵循“介入技術在惡性腫瘤綜合治療某一階段起主導作用”的理念,不斷強化惡性腫瘤“綜合”及“個體化”治療觀念,發揮多種治療手段的協同作用。並提出以“誘導、啟動、強化抗腫瘤自身免疫治療機制”為核心的多學科綜合綠色治療理念。
1、“微粒栓塞”治療各種實體惡性腫瘤,如原發性肝癌、肝轉移癌、肺癌、消化道腫瘤、卵巢癌、膀胱癌、宮頸 癌等。
2、微粒栓塞聯合自體免疫細胞治療技術治療各種惡性腫瘤。
3、治療各種難治性血管狹窄性疾病,如難治性糖尿病足、雙下肢動脈粥樣硬化性狹窄、腦動脈狹窄等疾病。
4、微粒栓塞治療各種肝血管瘤、子宮肌瘤、子宮腺肌症、皮膚蔓狀血管瘤等。
5、影像設備引導下穿刺治療各種轉移性淋巴結、胰腺癌、門靜脈癌栓及巨大肝、腎囊腫。
6、各種原因導致臟器動脈出血性疾病的急診介入栓塞技術。
7、支架成形術:治療各種膽道、氣管、食管、胃腸疾病導致管腔狹窄所致的梗阻性黃疸、氣管梗阻、食管梗阻、胃腸梗阻性疾病。
8、椎體成形術治療椎體轉移腫瘤、骨質疏鬆、壓縮性骨折導致的各種疼痛。
9、中心靜脈輸液港置入術:為長期、反覆輸液患者建立靜脈通道,減少反覆靜脈穿刺的痛苦及難度。
10、經皮腎盂造瘺術:治療各種原因引起的尿路梗阻及腎盂擴張。
典型病例介紹:
1.微粒栓塞治療巨塊型肝癌伴雙肺多發轉移

2.微粒栓塞治療巨塊型肝癌伴門靜脈主幹及左右支癌栓



大連大學附屬中山醫院開展的此項技術是將目前國內外通用的“自體免疫治療”概念進一步升華為“自體特異性免疫治療”,通過介入微創技術轉化出惡性腫瘤中積極信息,即暴露腫瘤特異性抗原,以此為起點,結合自體免疫細胞治療技術引導機體免疫系統特異性消滅腫瘤細胞,從而體現出“壞事變
培育的自體免疫細胞 光鏡圖與大連大學附屬中山醫院細胞生物實驗室主任袁小林教授及國內外多家細胞免疫研究機構共同開展自體免疫細胞技術的研發及臨床套用工作。對惡性腫瘤患者套用微粒栓塞惡性腫瘤供血動脈使體內迅速腫瘤細胞裂解,自體免疫細胞技術將體內暴露的腫瘤特異性抗原經樹突狀細胞(DC細胞)抗原呈遞作用,在體外擴增大量腫瘤特異性殺傷細胞(CIK),在回輸體內進行高效、特異性腫瘤免疫治療。
曾獲得的科研獎項:

2.《血管內治療症狀性腦血管痙攣的實驗和臨床研究》,2003年獲遼寧省政府科技進步三等獎
3.《大腸癌熱休克蛋白與耐藥、凋亡基因間關係及其臨床意義的研究》,2004年獲大連市政府科技進步二等獎
4.《血管內治療腦血管病的基礎和臨床研究》,1999年獲黑龍江省醫藥衛生科技進步一等獎
5.《血管內治療腦血管病的基礎和臨床研究》,2000年獲黑龍江省政府科技進步二等獎
6、 經皮經肝穿刺藥物注射治療惡性腫瘤的臨床研究,2011 大連市科技進步二等獎
7、超聲引導下經皮經肝治療肝門部轉移淋巴結的臨床套用 ,2011年遼寧省自然科學學術成果獎二等獎
獲得的榮譽稱號:
1.2002年獲2001年獲得“大連市友誼醫院科技興醫標兵"稱號
2.2002獲得大連市團委“大連市青年職工創新、創效能手”稱號
3.2004年入選遼寧省百千萬人才“千層次”人
4.2005年獲得“全國青年崗位能手”稱號
5.2006年被評為“享受大連市政府特殊津貼專家”
6.2008年獲得大連市第三屆青年科技獎
近年來發表文章及參編著作:
1.原發性肝癌介入治療的藥代動力學研究現狀,介入放射性雜誌,2011,20(9):749-752.
2.明膠海綿微粒經動脈栓塞治療原發性肝癌的研究現狀,介入放射性雜誌2011,20(12):1010-1013
3.明膠海綿微粒化療栓塞胃癌肝轉移療效的初步臨床研究,中國醫師進修雜誌,2011,34(26):9-11.
4.雙介入治療進展期胃癌幽門梗阻一例,世界華人消化雜誌,2011,19(11):1201.
5.超聲引導下經皮經肝治療肝門部轉移性淋巴結的臨床套用,介入放射學,2010,19(6):467-469.
6.新型明膠海綿顆粒栓塞劑在肝癌介入治療中的套用,中國新藥雜誌2010,19(17):1571-1574.
7.明膠海綿微粒化療栓塞巨塊型肝癌的療效觀察,當代醫學-中國介入放射學,2009,15(29):577-578.
8.經皮經肝穿刺注射碘化油化療藥物治療原發性肝癌門靜脈癌栓的臨床研究,中國介入影像與治療 學,2009,2:167-169.
9.區域動脈灌注聯合腹腔內化療及熱療治療進展期胃癌療效學觀察,中國介入放射學,2009.6(15)317-318.
10.大腸癌組織中Bcl-2表達與臨床病理參數相關性的研究,中華腫瘤防治雜誌,2007.1
11.大腸癌組織HSP27表達與臨床病理參數相關性的研究腫瘤學雜誌,2005.3
12.介入性化療治療轉移性多發惡性纖維組織細胞瘤一例報導,腫瘤學雜誌,2005.8
13.經皮椎體成形術及血管內栓塞化療治療椎體轉移瘤大連醫科大學學報,2005.5
14.腫瘤相關蛋白與胃癌淋巴結轉移的關係,臨床腫瘤學雜誌,2005.6
15.血管內治療症狀性腦血管痙攣的臨床研究,中華放射學雜誌,2003.1
16.椎動脈內灌注罌粟鹼治療症狀性腦血管痙攣的實驗研究,中華神經外科雜誌,2001.3
17.內皮素在血管內治療症狀性腦血管痙攣前後含量變化的實驗研究,臨床放射學雜誌,2001.7
18.HSP27在大腸癌及癌旁組織中的表達及其意義,臨床腫瘤學雜誌,2004.5
19.內皮素一氧化氮在蛛網膜下腔出血後腦血管痙攣中的動態變化,卒中與神經疾病,2000.4
20.建立一種新型的腦血管痙攣動物模型,哈爾濱醫科大學學報,2001.1 第一作者
21.Spetzler-MartinⅢ級以上腦動靜脈畸形綜合治療的臨床研究,中華神經外科疾病研究雜誌,2002.4
22.血管內新型液體栓塞劑的研製,哈爾濱醫科大學學報,2000.6
23.Experimental study of Eudragit mixture as a new nonadhesive liquid embolic material,Chinese Medical Journal,2002.4
24.血管內栓塞材料甲基丙烯酸共聚合物的實驗研究,中華實驗外科雜誌,2000.6
25.GDC栓塞治療後顱內動脈瘤的早期組織病理學改變,國外醫學-腦血管疾病分冊,1999.3
26.血管內治療顱內動脈瘤的實驗和臨床研究,國外醫學-腦血管疾病分冊,1998.3
27.症狀性腦血管痙攣血管內治療的研究進展,國外醫學-腦血管疾病分冊,1998.4
28.《醫學影像診斷學》 2006年科學技術文獻出版社 編委
作為課題負責人主持及指導的科研項目:
1.明膠海綿微粒化療栓塞肝癌術後T淋巴細胞亞群的變化,2012年院長基金
2.明膠海綿微粒TACE治療原發性肝癌術後Th-17細胞變化研究及意義,2012年院長基金
3.DynaCT重建技術在明膠海綿微粒化療栓塞肝癌術中的套用研究,2012年院長基金
4.明膠海綿微粒化療栓塞治療肝癌療效與外周血樹突狀細胞變化相關性研究,2011年院長基金項目
5. 外周動脈狹窄閉塞病變介入治療前後機體氧化應激水平變化的臨床研究,2011年院長基金項目
6. 明膠海綿微粒化療栓塞治療肝癌對機體樹突狀細胞影響的臨床及基礎研究,2010年大連市科委立項
7.局部注射P53-基因製劑與血管內化療藥物灌注序貫治療胰腺癌的臨床研究,2007年大連市衛生局科研立項
8.聯合套用基因製劑-P53經區域動脈化療栓塞治療進展期胃癌的臨床研究,2006年大連市科委立項
9.局部腦動脈移植神經幹細胞治療缺血性腦損傷的實驗研究,2004年大連市科委立項
10.介入治療重症胰腺炎的臨床研究,2002年大連市衛生局科研立項
11.遲發性腦血管痙攣血管內擴張治療的研究,1996年衛生部優秀青年人才專項基金
開展醫療新技術:
1.微粒聯合P53基因介入栓塞治療原發性肝癌
2.微粒栓塞聯合細胞免疫技術治療原發性肝癌
3.CT引導下經皮穿刺酒精注射治療腎上腺良性功能性腫瘤
4.移植腎動脈栓塞在失功移植腎處理中的套用
5.選擇性動脈栓塞和經皮注射平陽黴素治療頜面部蔓狀血管瘤
6.經皮門靜脈聯合注射P53及化療藥物治療原發性肝癌並門靜脈癌栓
7.經皮穿刺外引流術治療食管縱隔瘺後縱隔膿腔形成
